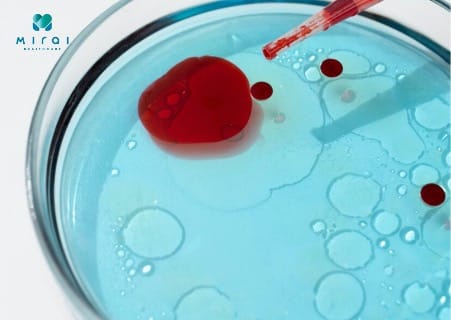
xet-nghiem-mau-co-phat-hien-ung-thu-mau-khong

Để chẩn đoán ung thư máu, các bác sĩ thường bắt đầu với xét nghiệm máu. Vậy, chỉ với một lần xét nghiệm máu có phát hiện ung thư máu không? Cùng tìm hiểu câu trả lời với TS, BS Phan Văn Mạnh – Bác sĩ chuyên khoa tại Phòng khám Mirai Healthcare với bài viết sau.
1. Xét nghiệm máu có phát hiện ung thư máu không?
Rất nhiều người thắc mắc, liệu xét nghiệm máu có phát hiện ung thư máu hay không. Theo TS, BS Phan Văn Mạnh – Bác sĩ chuyên khoa tại Phòng khám Mirai Healthcare cho biết, xét nghiệm máu là công cụ sàng lọc và chẩn đoán ban đầu rất quan trọng đối với ung thư máu, nhưng không phải là phương pháp duy nhất.
Xét nghiệm máu giúp đánh giá cơ bản tình trạng ung thư máu
Về cơ bản, xét nghiệm máu có thể phát hiện ung thư máu trong nhiều trường hợp, tuy nhiên một số thể bệnh cần thêm các xét nghiệm chuyên sâu khác để có chẩn đoán chính xác.
2. Một số xét nghiệm ung thư máu được chỉ định
Không chỉ xét nghiệm máu, để chẩn đoán chính xác bệnh lý ung thư máu bác sĩ sẽ chỉ định thực hiện các phương pháp sau:
2.1. Xét nghiệm máu
Phương pháp này là bước đầu tiên để sàng lọc ung thư máu. Bằng cách phân tích công thức máu hoặc phết máu ngoại biên, bác sĩ có thể phát hiện những bất thường về số lượng, hình dạng của các tế bào máu.
Ưu điểm của phương pháp này là nhanh, ít xâm lấn và chi phí thấp. Bạn có thể thực hiện lấy mẫu ngay tại nhà tiện lợi.
Xét nghiệm máu là bước cơ bản để sàng lọc ung thư máu
2.2. Sinh thiết tủy xương
Đây được coi là tiêu chuẩn vàng để chẩn đoán xác định ung thư máu. Bác sĩ sẽ lấy từ vùng xương chậu một mẫu tủy vừa đủ để phân tích.
Xét nghiệm này cung cấp thông tin chi tiết nhất về các tế bào ung thư, giúp xác định loại ung thư và giai đoạn bệnh. Toàn bộ quá trình từ lấy mẫu đến phân tích đều phải thực hiện tại bệnh viện.
2.3. Xét nghiệm hình ảnh
Các kỹ thuật chẩn đoán hình ảnh như chụp CT, MRI, PET-CT, siêu âm, X-quang không trực tiếp chẩn đoán ung thư máu, nhưng chúng có thể giúp phát hiện các khối u do ung thư máu di căn đến các cơ quan khác trong cơ thể.
Chụp CT giúp phát hiện khối u do ung thư máu di căn
Tóm lại, xét nghiệm máu là bước sàng lọc ban đầu rất hiệu quả, nhưng để có chẩn đoán xác định, đặc biệt với một số thể ung thư máu, các bác sĩ sẽ cần kết hợp thêm sinh thiết tủy xương và các xét nghiệm hình ảnh khác.
3. Ai nên xét nghiệm máu để sớm phát hiện ung thư máu?
Việc phát hiện sớm ung thư máu (bệnh bạch cầu) có ý nghĩa quyết định đến hiệu quả điều trị. Bạn nên chủ động xét nghiệm máu để tầm soát bệnh nếu thuộc một trong các nhóm dưới đây:
Khi xuất hiện những triệu chứng sức khỏe bất thường
- Mệt mỏi và sốt: Cảm thấy yếu ớt, mệt mỏi liên tục, kèm theo sốt, ớn lạnh, hoặc đổ mồ hôi đêm.
- Tổn thương da và chảy máu: Dễ bị bầm tím, chảy máu mũi thường xuyên, chảy máu chân răng hoặc có những đốm nhỏ màu đỏ/tím dưới da.
- Sưng hạch bạch huyết: Các hạch bạch huyết ở cổ, nách, bẹn sưng nhưng không gây đau.
- Các triệu chứng khác: Da tái nhợt, đau xương khớp, giảm cân không rõ nguyên nhân, hoặc nhiễm trùng thường xuyên và dai dẳng.
Thường xuyên mệt mỏi, sốt cần làm xét nghiệm ung thư máu
Kết quả xét nghiệm máu của một số chỉ số bất thường
Nếu kết quả xét nghiệm máu tổng quát cho thấy các chỉ số sau, bác sĩ có thể yêu cầu bạn làm thêm các xét nghiệm chuyên sâu hơn để loại trừ nguy cơ ung thư máu:
- Số lượng bạch cầu (WBC) bất thường.
- Số lượng hồng cầu (RBC) thấp và nồng độ Hemoglobin (HGB) giảm (tình trạng thiếu máu).
- Số lượng tiểu cầu (PLT) thấp.
- Xuất hiện các tế bào máu chưa trưởng thành (tế bào nguyên bào).
Nhóm nguy cơ cao
- Tiền sử điều trị: Đã từng hóa trị hoặc xạ trị trước đó.
- Di truyền: Có tiền sử gia đình mắc bệnh bạch cầu hoặc các hội chứng di truyền như Down, thiếu máu Fanconi, hội chứng Bloom.
- Môi trường sống: Thường xuyên tiếp xúc lâu dài với các hóa chất độc hại như benzen, bức xạ, hoặc hút thuốc lá.
Nếu đã từng mắc ung thư cần làm tầm soát ung thư máu
Xem thêm: Tầm soát ung thư là gì, 8 địa chỉ tầm soát ung thư tại Hà Nội
4. Khi xét nghiệm máu phát hiện ung thư máu nên làm gì?
Khi nhận được kết quả xét nghiệm máu nghi ngờ ung thư máu, điều quan trọng là bạn cần giữ bình tĩnh và thực hiện các bước sau để có chẩn đoán chính xác và kế hoạch điều trị hiệu quả.
- Gặp bác sĩ chuyên khoa: Hãy đến gặp bác sĩ chuyên khoa Huyết học – Ung bướu để được tư vấn và xác nhận lại chẩn đoán.
- Thực hiện sinh thiết tủy xương: Bác sĩ sẽ chỉ định sinh thiết tủy xương để xác định chính xác loại ung thư máu, mức độ và giai đoạn bệnh. Đây là “tiêu chuẩn vàng” để đưa ra phác đồ điều trị phù hợp.
- Tìm hiểu và thảo luận về bệnh: Hãy hỏi bác sĩ về tình trạng bệnh của bạn, các lựa chọn điều trị, và những tác dụng phụ có thể gặp phải. Việc hiểu rõ về bệnh sẽ giúp bạn và bác sĩ cùng đưa ra kế hoạch điều trị tối ưu nhất.
Nếu xét nghiệm phát hiện ung thư máu cần tư vấn thêm từ bác sĩ
Dù đối mặt với căn bệnh khó khăn, việc chủ động tìm kiếm sự giúp đỡ từ chuyên gia và tuân thủ điều trị sẽ giúp bạn có cơ hội chiến thắng bệnh tật.
5. Nên xét nghiệm máu ở đâu cho kết quả chính xác và nhanh chóng?
Để có kết quả xét nghiệm máu chính xác và nhanh chóng, bạn nên lựa chọn các cơ sở y tế uy tín, được nhiều người tin tưởng lựa chọn.
Mirai Healthcare là một trong những phòng khám đa khoa hàng đầu tại Hà Nội mà bạn có thể tin tưởng. Đây là thành viên của Tập đoàn y tế nổi tiếng Nhật Bản, với bề dày hơn 70 năm kinh nghiệm trong lĩnh vực xét nghiệm lâm sàng có tên Hoken Kagaku Kenkyujo.
Mirai Healthcare giúp bạn an tâm khi thực hiện xét nghiệm
Do đó, bạn có thể hoàn toàn an tâm khi xét nghiệm tại đây. Mirai Healthcare cam kết mang đến dịch vụ xét nghiệm máu chất lượng cao với những ưu điểm nổi bật:
Kết quả xét nghiệm nhanh, chuẩn
Phòng khám được trang bị hệ thống máy móc hiện đại đạt chuẩn quốc tế, giúp phân tích mẫu máu với độ chính xác và tốc độ vượt trội. Điển hình là Hệ thống ATELLICA này tích hợp ba module chính: Bộ xử lý mẫu, Máy phân tích sinh hóa và Máy phân tích miễn dịch.
Với khả năng tự động hóa hoàn toàn và xử lý đồng thời nhiều danh mục xét nghiệm (139 danh mục sinh hóa và 96 danh mục miễn dịch), hệ thống ATELLICA giảm thiểu tối đa sai sót, đảm bảo kết quả chính xác, đáng tin cậy.
Cùng công suất xử lý ấn tượng 500 mẫu/giờ và đạt công suất lên tới 1200 xét nghiệm sinh hóa/giờ và 440 xét nghiệm miễn dịch/giờ. Tốc độ này giúp rút ngắn thời gian chờ đợi, cho phép bác sĩ và bệnh nhân nhận được kết quả nhanh chóng, đặc biệt quan trọng trong các trường hợp cần chẩn đoán khẩn cấp.
Mirai Healthcare có máy hiện đại – kết quả khám nhanh, chuẩn
Bác sĩ nhiều năm kinh nghiệm:
Các bác sĩ tại Mirai Healthcare có chuyên môn cao, đảm bảo quy trình lấy mẫu và phân tích khoa học, đồng thời đưa ra những tư vấn chuyên sâu sau khi có kết quả.
Tiện lợi và linh hoạt:
Bạn có thể dễ dàng đặt lịch hẹn trước, không phải chờ đợi lâu. Ngoài ra, Mirai còn cung cấp dịch vụ lấy mẫu xét nghiệm tại nhà miễn phí, rất thuận tiện cho những người bận rộn.
Với sự kết hợp giữa chất lượng y khoa chuẩn Nhật Bản và dịch vụ chuyên nghiệp, Mirai Healthcare là đối tác đáng tin cậy giúp bạn chủ động chăm sóc và bảo vệ sức khỏe của mình một cách toàn diện.
Như vậy, xét nghiệm máu có phát hiện ung thư máu không đã có câu trả lời với bài viết trên. Đây là xét nghiệm sàng lọc ban đầu rất quan trọng trong việc phát hiện ung thư máu và gợi ý cho bác sĩ chỉ định thêm các phương pháp chẩn đoán chuyên sâu để đưa ra kết luận cuối cùng.
Khi cần xét nghiệm máu để tầm soát ung thư máu, bạn nên lựa chọn các cơ sở y tế uy tín như Mirai Healthcare để có kết quả chính xác, nhanh chóng. Hãy inbox ngay cho Mirai Healthcare trên website https://miraihealthcare.vn/ hoặc Hotline 19009186 để đặt lịch khám và được tư vấn miễn phí.